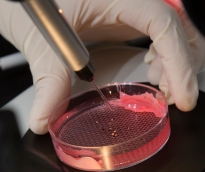
alsharq

أعلنت وزارة التربية والتعليم والتعليم العالي اعتماد التوقيت الصيفي لدوام المدارس الحكومية اعتبارًا من 3 مايو وحتى 3 يونيو 2026. ويبدأ اليوم الدراسي...
رئيس مجلس الإدارة : د. خالد بن ثاني آل ثاني

رئيس التحرير: جابر سالم الحرمي

مساحة إعلانية

كشفت دراسة حديثة أجرتها وايل كورنيل للطب - قطر أن عدوى الكلاميديا تعد إحدى الأسباب الرئيسة للعقم بين عامة سكان منطقة الشرق الأوسط وشمال إفريقيا، كما لاحظت الدراسة معدلات إصابة ومستويات مرتفعة غير متوقعة من هذه العدوى، بين النساء المصابات بالعقم أو اللاتي يعانين مضاعفات وتعقيدات خلال الحمل. وتصيب عدوى الكلاميديا المسالك التناسلية وتنتقل عادة، عن طريق الاتصال الجنسي وعندما تصاب المرأة بها، تنتقل البكتيريا إلى الأعضاء التناسلية الداخلية، مما يتسبب في إتلافها، ومن ثم في صعوبة الحمل عند المرأة المصابة بها. استندت الدراسة الموسعة التي جاءت تحت عنوان تقييم انتشار وباء الكلاميديا تراكوماتس في الشرق الأوسط وشمال أفريقيا: دراسة منهجية وتحليلات إحصائية معمقة وبتمويل من الصندوق القطري لرعاية البحث العلمي، إلى دراسة استقصائية متعمقة أجريت على مدار أعوام عدة بالاستعانة ببيانات أكثر من 250 ألف فرد من 20 دولة من أصل 23 دولة في منطقة الشرق الأوسط وشمال أفريقيا. وتمثل هذه الدراسة السباقة أول دراسة ترصد وتصف مستويات الإصابة بعدوى الكلاميديا بشكل مفصل في هذه المنطقة. وأشارت الدراسة إلى أن قرابة 3 بالمائة من سكان منطقة الشرق الأوسط وشمال إفريقيا مصابون حاليا ببكتيريا الكلاميديا، وهذه النسبة مشابهة للنسب المرصودة في مناطق أخرى من العالم. ووجدت الدراسة أن معدلات الإصابة بالكلاميديا بقيت على حالها طوال العقود الثلاثة الماضية على الأقل. كما كشفت الدراسة أن معدل الإصابة بين المصابين بالعقم هو 11 بالمائة وبين النساء اللاتي تعرضن للإجهاض تلقائيا هو 12 بالمائة، مما يبرز تأثير هذه العدوى على الصحة الإنجابية للمرأة. وعلى الرغم من الطبيعة الملحة لهذه المشكلة الصحية، تكاد لا توجد برامج صحة عامة في بلدان الشرق الأوسط وشمال أفريقيا مكرسة للتصدي لهذه العدوى. وأوضحت الدراسة أن برامج الفحص المبكر للكلاميديا وعلاجها يعد إجراء روتينيا متبعا في العديد من البلدان المتقدمة، ورغم ذلك قلما نراها في بلدان منطقة الشرق الأوسط وشمال أفريقيا. وأشارت الدراسة إلى أن عدم وجود مثل هذه البرامج ربما يكون السبب الرئيسي وراء المستويات المرتفعة لانتشار المرض حيث يحمل الأفراد المصابون هذه البكتيريا لفترة زمنية طويلة، وينقلون العدوى إلى المزيد من الأفراد قبل تشخيص المرض وعلاجه. وفي هذا الصدد أوضحت الباحثة هيام الشميطلي، المؤلفة الرئيسية للدراسة والأخصائية في علم الوبائيات في وايل كورنيل للطب - قطر، أن معدلات العقم بين النساء في منطقة الشرق الأوسط وشمال أفريقيا هي من الأعلى عالميا، غير أن الأسباب الكامنة وراء ذلك تظل مبهمة حتى جاءت هذه الدراسة الفريدة التي لفتت إلى أن عدوى الكلاميديا هي إحدى الأسباب الرئيسية للعقم في المنطقة
683
| 18 أغسطس 2019

يواصل طلاب الطب في وايل كورنيل للطب - قطر المراحل المتتالية من التدريب المكثف، وقد خاضوا مؤخراً تجربة التعامل مع شريحة يُعتقد أنها الأكثر إثارة للاهتمام والأصعب في التنبؤ بتصرفاتها في آنٍ معاً، ألا وهي شريحة صغار الأطفال. فقد شارك طلاب الطب - سنة ثالثة في برنامج الطب بالأسبوع التوجيهي الإكلينيكي الذي شمل فعالية نجوم كورنيل السنوية، لإعدادهم بالشكل الأمثل لبدء المساقات الإكلينيكية المتفرغة، وفي هذا الإطار، أحضر أعضاء الهيئتين التدريسية والإدارية في الكلية أطفالهم ليتمكّن طلاب الطب من اكتساب أفضل أساليب فحص الأطفال ضمن بيئة طبية. وأُجريت الفحوص كافة في مختبر المهارات الإكلينيكية والمحاكاة في وايل كورنيل، الذي يتضمّن العديد من العيادات المحاكية للعيادات الفعلية. ونوّهت الدكتورة أمل خضر، الأستاذ المشارك لطب الأطفال في وايل كورنيل ومنظِّمة فعالية نجوم كورنيل، بأهمية هذه الفعالية السنوية واصفة إياها بفرصة تعلُّم قيمة لطلاب الكلية، فخلالها يعرفون عن قُرب أوجه التباين بين فحص البالغين وفحص الأطفال وكذلك أوجه الاختلاف في التعامل مع هاتين الشريحتين، ومثالاً على ذلك أن الطفل قد يستلزم تشجيعاً من طبيبه وعوناً من أحد أبويه مثلما يتعيّن أن يكون الطبيب نفسه مرناً يمكنه أن ينتهز أي فرصة سانحة في حينه. قالت الدكتورة خضر: الهدف الأول من هذه الفعالية هو إتاحة الفرصة لطلاب الطب للتفاعل مع صغار الأطفال وإجراء الفحوص البدنية الأساسية لهم في تجربة محاكِية للتجربة الواقعية، وفي الوقت نفسه تمرير العديد من التلميحات والمعلومات المفيدة التي يمكن أن تساعدهم في إجراء الفحوص اللازمة. وعلى سبيل المثال، نوضح لطلابنا كيفية طمأنة الطفل ومن ثم امتثاله، وقد يتحقق ذلك بتمكينه من الإصغاء إلى دقات قلبه عبر سماعة الطبيب، مثلما نشرح لهم أيضاً كيفية بناء علاقة ودّية معه. وفي نهاية المطاف، نريد أن يتعلّم طلابنا كيفية التفاهم والتواصل والتفاعل مع الأطفال وذويهم بطريقة مبدعة وخالية من التوتر. أشرف على الفحوص السريرية أطباء من وايل كورنيل للطب - قطر، مؤسسة حمد الطبية ومركز سدرة للطب، حيث نقلوا تجاربهم الطويلة والمتعمقة في مجال طب الأطفال إلى الطلاب المشاركين.
819
| 24 يونيو 2019

قدم طلاب البرنامج التأسيسي في وايل كورنيل للطب ملصقات بحثية حول تجربتهم في برنامج مرافقة الأطباء وأصحاب المهن الطبية أثناء جولاتهم اليومية على المرضى في سدرة للطب، وهذا البرنامج هو جزء من منهج اللغة الإنجليزية التي يدرّسها الدكتور رشيد بن ادريس، حيث يتمكن الطلاب من اختبار كيفية تعاطي الأطباء مع المرضى ومع زملائهم الأطباء ومع ممارسي المهن الصحية في المستشفى. وقد اختار كل طالب من البرنامج التأسيسي موضوعاً من بين 5 مواضيع بنى عليه ملصقه البحثي، وهذه المواضيع هي: العمل بروح الفريق الواحد، القيادة، التعاطف، الذكاء العاطفي والاحتراف المهني. وركّز الطلاب خلال الفصل الدراسي المواضيع التي اختاروها متعمقين فيها من خلال الاطلاع على البحوث المنشورة حولها وإجراء الحوارات في ما بينهم وعبر الإنترنت، وفي نهاية الفصل الدراسي، شاركوا ببرنامج المرافقة في سدرة وحضّروا الملصقات المطلوبة منهم مستندين إلى مراجعة الإنتاج الفكري وإلى مشاهداتهم واستنتاجاتهم، كما ضمّنوا الملصق تحليلاً للرسوم البيانية. قال الطالب خالد الصباغ إنّ العمل ركز على روح الفريق الواحد وخاض تجربة مرافقة الأطباء وأصحاب المهن الطبية في قسم الجراحة العامة في سدرة للطب. أما الملصق البحثي الذي نفّذه، فكان حول العمل بروح الفريق الواحد ضمن تخصصات ومهن مختلفة ومتقاطعة في القطاع الطبي. وقال عن تجربته: ركزت على مرافقة العمل بروح الفريق الواحد والفوائد التي تنعكس على صحة المرضى والنتائج الإيجابية ومستوى الرضا. وخلصت إلى أن العمل بروح الفريق الواحد خصوصاً ضمن تخصصات ومهن مختلفة ومتقاطعة في القطاع الطبي، مهم جداً لتحسين صحة المرضى. كما لاحظت أن الفريق الطبي لا يكرّس التراتبية الوظيفية، فكل شخص يساعد ويعمل بروح الفريق الواحد ويتحمل مسؤولياته ومسؤوليات غيره من أعضاء الفريق. أما الطالبة لطيفة محمود فقد شاركت في برنامج المرافقة ضمن قسم أمراض النساء والتوليد في سدرة للطب، وقالت عن هذه التجربة: لقد تأكدت بأنه لا يوجد وصف حصري للمهنية بل على العكس، تتجلّى ميزتها في عدة طرق حسب الطبيب والظروف التي يمرّ بها المريض. فالمهنية ليس لديها تعريف، فكل طبيب لديه طريقته بأداء مهامه وبإظهار مهنيته، منهم بطريقة كلامهم مع المرضى ومنهم بطريقة الشرح وإجراء التدخلات الجراحية وغيرها من طرق العلاج. وقال الدكتور رشيد بن ادريس، العميد المساعد لاستقطاب الطلاب والتواصل المجتمعي والبرنامج التأسيسي: كانت تجربة قيّمة بالنسبة للطلاب وكانت المواضيع التي ركزوا عليها في صلب الأمور المطلوبة للتميّز في الرعاية الصحية. وهذه التجربة مختلفة عن برنامج مرافقة الأطباء الإكلينيكي، إذ أنها تشجعهم على تبنّي النهج الحاسم والدقيق وعلى التركيز على ميزات أصحاب مهن الرعاية الصحية الذين ليسوا جزءاً من المناهج الطبية التقليدية. وأظهرت الملصقات البحثية مستوى عاليا لدى الطلاب وإدراكهم بأن الطبيب الجيد لا يتطلب فقط أن يجتاز الامتحانات بنجاح. نفّذ هذا البرنامج بدعم من المكتبة في وايل كورنيل للطب وقسم شؤون الخريجين وقسم التعليم الطبي في سدرة للطب.
568
| 12 يونيو 2019

حقّق الدكتور رياز مالك، أستاذ الطب في وايل كورنيل للطب - قطر، إنجازين عالميين رفيعين متعاقبين هذا العام يستحقان الثناء والاحتفاء بهما. فقد احتلّ المرتبة الثانية ضمن قائمة العلماء الأكثر تأثيراً في مجال مضاعفات السكري على مستوى المملكة المتحدة والتي يعدّها وينشرها مؤشر Expertscape، الأبرز في العالم لتقييم الإنجازات والخبرات الأكاديمية في مجال الطب والرعاية الصحية. ويصنّف المؤشر المذكور أداء الباحثين على نحو محايدٍ بالاستناد إلى سلسلة من المقاييس الموضوعية من أجل تقييم عددِ ورصانة الأوراق البحثية المنشورة وعامل التأثير للدوريات العلمية والطبية التي نُشرت فيها تلك الأوراق البحثية طوال الأعوام العشرة الماضية. ورغم أنّ الدكتور مالك انتقل من المملكة المتحدة إلى دولة قطر في عام 2014 للانضمام إلى الهيئة التدريسية في وايل كورنيل للطب - قطر إلا أنه ما يزال يشغل منصب الأستاذية الفخرية في جامعة مانشستر، ما يجعل مؤشر المملكة المتحدة ينطبق عليهِ. ثم نال في وقت لاحق جائزة كاميلو غولجي العالمية المرموقة لإسهاماته البحثية الثرية في مجال الأبعاد المرضيّة النسيجية لداء السكري ونشوئه وسُبل الوقاية منه وعلاجه ومضاعفاته. وتحمل الجائزة اسم الطبيب والبيولوجي الإيطالي الشهير كاميلو غولجي الذي نال جائزة نوبل في عام 1906 عن بحوثه في مجال الجهاز العصبي وفسيولوجية الكُليتين، وتمنح الجائزة الجمعية الأوروبية لدراسة السكري (EASD).
715
| 21 مايو 2019

حاضر الدكتور جون ماهوني، العميد المشارك لتعليم الطب في كلية طب جامعة بيتسبرغ بولاية بنسلفانيا، حول التحديات الجمّة الماثلة أمام الأكاديميين والتربويين بفعل التباين بين الأجيال المتعاقبة. وتحدث ماهوني خلال محاضرة دعا إليها قسم التعليم الطبي المستمر في وايل كورنيل للطب - قطر حول السمات الثقافية والشخصية المتفاوتة بين أبناء جيل طفرة المواليد، والجيل إِكْس، وجيل الألفية، والجيل زِدْ، إنما تؤثر في طريقة دراسة كل مجموعة، وطريقة تعلُّمها وتفاعلها، موضحاً التحديات والفرص الناشئة عن تلك الاختلافات. ويُقصد بجيل طفرة المواليد الفئة السكانية المولودة بين عامي 1946-1964، وبجيل إِكْس الفئة السكانية المولودة بين عامي 1965-1980، وبجيل الألفية الفئة السكانية المولودة بين عامي 1981-1994، وبجيل زِدْ الفئة السكانية المولودة بين عامي 1994-2012. وقال الدكتور ماهوني إن كل جيل ينفرد بسماته الخاصة وقيمه الثقافية وعاداته في بيئة العمل، وناقش في السياق نفسه سُبل إثراء التواصل في ما بين الأجيال المختلفة بما يعزّز نواتج العملية التدريسية. وأشار المحاضر إلى أنّ أحد أبرز الفروق بين الأجيال هو موقف كل جيل إزاء التكنولوجيا، وقال في هذا الإطار: عند مواجهة مشكلة ما، لا تمثّل الاستعانة بالتكنولوجيا الخيار الأول أو أحد الحلول الحدسية أو البديهية عند كثيرين من أبناء الأجيال المتقدمة في السن، فيما تمثّل التكنولوجيا الحل الأول عند الجيل الأصغر سناً. وفي حين ينظر أبناء جيل الألفية إلى التكنولوجيا كحاجة أساسية، نجد فرقاً دقيقاً بينهم وبين أبناء الجيل بالإضافة إلى الذين كبروا محاطين بالتكنولوجيا من كل صوب، فهؤلاء لا يقدّرون قيمة وأهمية الاتصال والتواصل فحسب، بل يفترضون أن الاتصال بالإنترنت هو أحد حقوقهم. فمثل هذه الأشياء تمثّل على الدوام جانباً أساسياً من حياتهم اليومية، وهذا يؤثر في الطريقة التي ينظرون فيها إلى العالم وإلى التعلُّم أيضاً.
979
| 18 مايو 2019

ناقشت الدكتورة سمية زاهروفيتش، الأستاذ المساعد للطب في وايل كورنيل للطب - قطر، الأسباب المحتملة المختلفة لآلام أسفل الظهر، وذلك في إطار سلسلة المحاضرات المتخصصة التي يستضيفها قسم التعليم الطبي المستمر في الكلية. وقد أوضحت زاهروفيتش أن آلام أسفل الظهر هي عَرَض مرض وليست مرضاً بحدّ ذاتها، وقد يتسبّب بها عامل أو عوامل مجتمعة يمكن تصنيفها بالعوامل الميكانيكية والجهازية والعصبية، وتشمل العوامل الميكانيكية، على سبيل المثال، العضلات أو الأربطة المشدودة أو المجهدة، والأقراص القَطَنية المتفتقة أو المتنكسة، وخلل عمل المفاصل. فيما تشمل العوامل الجهازية الاضطرابات المناعية مثل الاعتلالات الفقارية المحورية (وهي حالة التهاب مفاصل تتسم بالتهاب المفاصل ومن ثم إمكانية تثبيت المفاصل)، من شأنها أن تسبّب ألماً مزمناً في أسفل الظهر، مثلها مثل مرض هشاشة العظام حيث تكون العظام هشة إلى درجة تكون معها عُرضة للكسر بسهولة، ما يتسبّب بفقدان جزء من طول الجسم إلى جانب تفاقم خطر الإصابة بكسور العمود الفقري والورك. وقدّمت الدكتورة زاهروفيتش، التي تخرّجت في وايل كورنيل للطب - قطر، توضيحاً تقنياً مفصّلاً عن الأدوات التشخيصية المختلفة المتاحة للأطباء عند استقصاء آلام أسفل الظهر، ابتداء من المعاينة البدنية ومناقشة المريض في طبيعة الألم، وانتهاء بالأشعة السينية والتصوير بالرنين المغناطيسي وحُقن العمود الفقري التشخيصية وغيرها. وقالت المحاضرة إنّ من شأن منهجية ميكانيكية أكثر دقة في تشخيص أسباب آلام أسفل الظهر أن تقود إلى علاجات أكثر دقة في المستقبل. وختمت قائلة: بسبب الأسباب المحتملة المتعددة لآلام أسفل الظهر يجب أن يعتمد تشخيص تلك الآلام منهجية متعددة الأوجه تنظر بإمعان في مجموعة من الأعراض والعلامات المرضيّة، ويتعيّن على الأطباء إجراء متابعة منتظمة لمرضاهم الذين يعانون آلاماً في أسفل الظهر لا تعود إلى أسباب واضحة، وقد يتوصل هؤلاء الأطباء إلى تشخيصٍ من خلال المراقبة الوثيقة المتواصلة. نالت المحاضرة الاعتمادين اللازمين من إدارة الاعتماد في المجلس القطري للتخصصات الصحية في قطر ومجلس اعتماد التعليم الطبي المستمر في الولايات المتحدة.
1186
| 14 مايو 2019

نظمت الجمعية القطرية للسرطان ومجموعة طلاب من وايل كورنيل للطب – قطر حملة توعوية استمرت من شهر فبراير وحتى أبريل الماضي تحت عنوان قطر تتحدّى السرطان، وقد هدفت الحملة إلى رفع الوعي بالمرض وتعزيز ونشر ثقافة الكشف المبكر عنه وجمع التبرعات لصالح الجمعية للمساهمة في علاج المرضى ودعم الأنشطة والبرامج التوعوية. واختتمت بفعالية عقدت على مدار يومين في ساحة الاحتفالات في المدينة التعليمية، وقد شدّدت الجهات المنظمة على أهمية الكشف المبكر عن السرطان، وتمكّن المشاركون من طرح الأسئلة على المنظمين حول علامات وأعراض الإصابة بالسرطان وعوامل الخطورة وطرق الوقاية. وتعتبر هذه الفعالية جزءاً من برنامج توعوي تقوده الطالبتان في وايل كورنيل للطب – قطر نور طريفي وآية يوسف رئيسة مجموعة الطلاب المهتمين بأمراض الدم والأورام التي قالت: نجحنا بتنظيم فعاليات توعوية حول سرطان الثدي واستطعنا جميع التبرعات لصالح الجمعية القطرية للسرطان وصلت إلى اربعمائة واربعين الف ريال قطري، لذلك قررنا أن تكون الفعاليات التي ننظمها أكثر شمولية نتطرّق فيها ليس فقط لسرطان الثدي، بل لأمراض السرطان الشائعة في قطر، مضيفة لقد شارك معنا أطباء ومثقفون صحيون من سدرة للطب ومؤسسة حمد الطبية والجمعية القطرية للسرطان الذين كرّسوا خبرتهم ومعرفتهم للردّ على استفسارات الحضور. نأمل من تنظيم هذه الفعاليات التي تستهدف أفراد المجتمع القطري في تجسير الهوة بين طلاب الطب والمجتمع وأن يكون للطلاب أثر إيجابي بتعزيز صحة وعافية أفراد المجتمع. وقال السيد زكريا كرزون –مسؤول التسويق والشراكات بالجمعية القطرية للسرطان ان تنظيم هذه الحملة يأتي تماشياً مع رؤية قطر الوطنية 2030 التي أولت اهتماما كبيراً بصحة الانسان وأهمية الاستثمار في العنصر البشري من خلال التأكيد على أهمية الوقاية عبر اطلاق حملات دورية وفعاليات توعوية مكثفة تهدف إلى نشر الوعي بالمرض وطرق الوقاية منه والتخفيف من أعباء المرض لاسيما ان رؤية الجمعية أن تكون منصة الشراكة المجتمعية لجعل قطر رائدة في مجال الوقاية من السرطان وتخفيف آثاره ورسالتها نحو السعي للوقاية من السرطان وتخفيف آثاره في قطر، من خلال العمل مع شركائها لتوعية المجتمع، ودعم وتمكين ومناصرة المتعايشين مع المرض، والتطوير المهني والبحث العلمي في مجال السرطان، لافتاً إلى أن ما حققته الجمعية من انتشار في المجتمع يؤكد أن الدعم الممنوح من قبل المؤسسات يؤتي ثماره، مشيراً إلى ان إطلاق هذه المبادرة من شأنه المساهمة في حماية مستقبل الأجيال القادمة عبر خلق جيل واع لا يحمل مخاوف من مرض السرطان، مؤكداً التزام الجمعية بدعم كافة المبادرات والحملات التوعوية التي تطلقها جميع الجهات عبر حملات توعوية هادفة للوقاية من السرطان.
1752
| 02 مايو 2019

استضافت وايل كورنيل الملتقى البحثي السنوي في نسخته التاسعة، ونوقشت خلاله أحدث تطورات علوم الطب الحيوي بحضور علماء وباحثين يمثلون نخبة من أهم المؤسسات البحثية والعلمية في قطر. وحضر أكثر من 200 من العلماء الرياديين وطلاب الطب في وايل كورنيل للطب والمهتمين والمعنيين ببحوث الطب الحيوي أعمال الملتقى للتعريف بمشروعاتهم البحثية، ومناقشة الاتجاهات الراهنة في بحوث الطب الحيوي، والإصغاء إلى محاضرات ألقاها زملاء لهم من العلماء والباحثين الاستقصائيين، والمشاركة في مسابقة الملصقات البحثية. وأما المحاور البحثية لمنتدى هذا العام فشملت داء السكري، السمنة، الأمراض العصبية، علم الجينوم، سرطان الثدي، إيكولوجية قطر، الصرع، أمراض القلب والأوعية الدموية، إلى جانب عدد آخر من المحاور. ويُعدّ الملتقى البحثي للكلية أحد أهم الأحداث العلمية السنوية المرتقبة في الأوساط العلمية في قطر والمنطقة، وانصبّ تركيز نسخة هذا العام على ترجمة الاكتشافات والابتكارات العلمية إلى مشروعات تجارية ناجحة. وفي مستهل أعمال الملتقى قال الدكتور جاويد شيخ عميد وايل كورنيل للطب - قطر، في كلمته الافتتاحية: قطعت قطر شوطاً واسعاً في ترسيخ قطاع ناجح في مجال بحوث الطب الحيوي. وثمة تحدّ ماثل أمامنا يتمثل في استقطاب رؤوس الأموال الاستثمارية الكافية من القطاع الخاص بما يمنح الزخم اللازم للشركات الصغيرة والمتوسطة، فهي ضرورية لنقل الابتكارات من المختبرات إلى الأسواق. وهذه خطوة حاسمة الأهمية إذا ما أرادت قطر أن تتحول نحو اقتصاد المعرفة المستدام.
1005
| 06 أبريل 2019

نظّم قسم شؤون الخريجين في وايل كورنيل دورة تدريبية لمدة سبعة أيام تدرب خلالها بعض خرّيجي الكلية الذين يعملون في قطر على مجموعة متكاملة من مهارات القيادة والإدارة. فقد أتمّ عشرة خريجين برنامج شهادة القيادة والإدارة بعد أن تدربوا طوال أسبوع كامل على نطاق عريض من المحاور شملت على سبيل المثال لا الحصر الأساليب المختلفة المتبعة في عالم الإدارة، إدارة الأداء والتحفيز، مهارات عرض الأفكار والاتصال، دور التدريب والتوجيه، أدوات اتخاذ القرار، الذكاء العاطفي، وكيفية تعزيز الإصرار والتصميم. وأدارت البرنامج مؤسسة Leadership Focus، وهي مؤسسة تدريبية متخصصة مقرّها العاصمة البريطانية لندن، والبرنامج معتمد من معهد القيادة والإدارة (ILM) في المملكة المتحدة. والخريجون العشرة الذين حضروا الدورة التدريبية تخرجوا في وايل كورنيل للطب - قطر بين عامَي 2009 و 2016 ويشغلون حالياً مناصب مختلفة، فمن بينهم استشاريون وأساتذة مساعدون وأطباء زملاء وأطباء مقيمون أوائل، وهم يعملون في مؤسسات قطرية مختلفة تشمل وايل كورنيل ومؤسسة حمد الطبية وسدرة للطب. وأما تخصصاتهم الدقيقة فتشمل طب الأطفال، الطب الباطني، طب الطوارئ، طب أشعة الأطفال، أمراض النساء والتوليد، والطب النفسي. قال الدكتور روبرت كرون نائب العميد لشؤون هيئة التدريس في وايل كورنيل: لا نخرّج أطباء على مستوى عالٍ من التعليم فقط، إنما نؤسس لجيل المستقبل من قادة الرعاية الصحية في قطر. ويعني هذا الأمر أنه يجب علينا البقاء على تواصل دائم بخرّيجينا الذين يتابعون تخصصاتهم الطبية العالية في قطر وفي أميركا الشمالية وتشجيعهم على العودة إلى قطر للعمل فيها ولاستلام مناصب مهمة في منظومة الرعاية الصحية.
752
| 23 مارس 2019

مها النشار: تكثيف عمليات التدريب وإكساب المترجمين الطبيين خبرة ميدانية أطلقت جامعة وايل كورنيل للطب قطر مبادرة تجسير الهوة لتدريب المترجمين الطبيين، وتعزيز التواصل بين مزودي الخدمات الصحية من جهة والمرضى من جهة أخرى. وهو البرنامج التدريبي الرائد الذي أطلقه مركز الكفاءة الثقافية في الرعاية الصحية، التابع لقسم الصحة العالمية والعامة في وايل كورنيل، الجامعة الشريكة لمؤسسة قطر، والذي يهدف إلى تعزيز التواصل اللغوي والثقافي بين مزودي الرعاية الصحية من أطباء وممرضين وفنيين وعاملين في هذا القطاع، وبين مختلف أفراد المجتمع لا سيّما المرضى وأُسرهم. ويتوجه برنامج تجسير الهوة غير الربحي لجميع العاملين بالمجال الطبي في القطاعين العام والخاص، من أطباء، وصيادلة، وممرضين وممرضات، وتقنيين. منذ إطلاقه عام 2012 حقق برنامج تجسير الهوّة نجاحا لافتا، كما أحدث تأثيرات إيجابية في قطاع الرعاية الصحية، حيث يُساهم خريجو هذا البرنامج والبالغ عددهم 288 يتوزعون على 22 لغة في تقليص الهوّة بين مزودي الرعاية الصحية والمريض، من خلال تطوعهم في المؤسسات الطبية الحكومية والخاصة، في سبيل مساندة الأطباء والمرضى على التواصل بشكل أفضل عبر الترجمة الطبية ومراعاة الاختلافات الثقافية. وتعدّ اللغة وسيلة مهمّة للتواصل بين الأفراد خصوصًا في المجتمع التي تتعدد فيه اللغات وتتنوع فيه الثقافات، ومن هنا تكمن أهمية الترجمة التي لا تقتصر على مجال محدد، وإنما تشمل أهميتها مختلف المجالات خصوصا في مجال الرعاية الصحية، حيث إن تعزيز التواصل بين مزودي خدمات الرعاية الصحية من جهة والمرضى وأسرهم من جهة أخرى، يعد عاملا رئيسيا في تحقيق التقدّم المطلوب على المستوى الصحي في مجتمع متعدد الثقافات. وكأي مجال آخر، تتطلب الترجمة الطبية الحصول على التدريب الأمثل من أجل صقل وتطوير المهارات اللغوية. لذا، قامت الجامعة بهذه المبادرة. قالت السيدة مها النشار، مديرة مركز التوعية الثقافية في الرعاية الصحية التابع لقسم الصحة السكانية في وايل كورنيل: يهدف برنامج تجسير الهوة إلى تعزيز التواصل بين الثقافات من أجل المساهمة في تقديم رعاية صحية أكثر فاعلية. ونحن نتطلع إلى تعزيز التعاون مع المؤسسات الطبية في القطاعين الحكومي والخاص، من أجل الاستخدام الأمثل لمهارات خريجي هذا البرنامج والمحافظة عليها في الوقت نفسه، من حيث تكثيف عمليات التدريب وإكساب المترجمين الطبيين خبرة ميدانية، وذلك في إطار تحقيق أحد أهداف رؤية قطر الوطنية بإرساء نظام شامل للرعاية الصحية يواكب أفضل المعايير العالمية ويمكن جميع السكان من الوصول إليه والانتفاع بخدماته. وأضافت: نسعى إلى العمل مع المؤسسات الصحية إقليمية ودولية، من أجل تعزيز التواصل الثقافي بين العاملين في قطاع الرعاية الصحية، ولهذا فإن هذا البرنامج سيُساهم في تقليص حاجز اللغة وتخطيه، من أجل مجتمع مُستدام صحيّ ومعافى. من جهتها، قالت الدكتورة آلاء سليمان، وهي طبيبة وباحثة، وعضو في لجنة التخطيط العلمية الخاصة بالبرنامج: انطلاقًا من مهنتي كطبيبة أطفال، أنا على دراية بالمصطلحات الطبية وكنتُ على تواصل مستمر مع المرضى وعائلاتهم باستمرار. ومع ذلك، فإن العديد من العوامل تلعب دورا في نجاحنا بتفسير المصطلحات الطبية بخلاف المصطلحات المحكية. ومن بين هذه العوامل، الموضوعية قدر الإمكان في نقل الحالة الطبية لعائلة المريض كما هي، ومراعاة اختلاف الثقافات، وتحقيق المساواة في تقديم الخدمة الطبية بين الجميع. إن التحدّث بلغة المريض ضرورية للحصول على أفضل النتائج، وهو ضروري أيضًا كجسر للتواصل مع الثقافات الأخرى. وأضافت: إن تجربتي في هذا البرنامج، تجاوزت توقعاتي، وأضافت الكثير إلى مهاراتي كممارس طبي تعلّم أسس دور المترجم الطبي، وأصبحتُ اليوم على دراية أكثر عمقا بمهمة ومسؤوليات المترجم الطبي، الذي يُساهم وبشكل كبير في تقليص الفجوة بين المرضى ومقدمي الرعاية الصحية، ويُساهم أيضًا في تعزيز التوعية بأهمية دوره في مجتمع يستقطب جنسيات مختلفة، ويوفر الخدمة الطبية للجميع على حدّ سواء وهذا ما يتطلب وجود مترجمين مدربّين على أفضل الممارسات الطبية. ويتبين التأثير الفعلي لهذا البرنامج في حرص بعض المؤسسات الطبية المحلية على تدريب موظفيها كأحد المعايير الرئيسية لتحقيق التطوير المهني المنشود، حيث يتيح برنامج تجسير الهوّة للمتدربين والمهنيين في قطر اكتشاف وتعلّم المصطلحات الطبية بلغات مختلفة، والتعرف على اختلاف الثقافات في هذا المجال، وتقليص الحواجز اللغوية بما يلبي مساعي مؤسسة قطر في دعمها لمسيرة قطر نحو اقتصاد مستدام.
1358
| 22 مارس 2019

تعتزم إدارة رعاية العمال باللجنة العليا للمشاريع والإرث بالتعاون مع وايل كورنيل للطب - قطر، إطلاق مشروع لمراقبة صحة عمال مشاريع بطولة كأس العالم لكرة القدم قطر 2022 لمدة ثلاثة أعوام، وذلك في إطار جهودها الرامية لتحسين صحة العمال طوال فترة عملهم في قطر. وسيستخدم خبراء ومتخصصون في وايل كورنيل تقنيات طبية حديثة لمراقبة وتقييم المؤشرات الصحية الأساسية لدى العمال، كمعدل ضربات القلب، ونسبة السكر في الدم، ومعدل ضغط الدم، ودرجة حرارة الجسم، ونسبة الماء في الجسم، وغيرها. علاوة على ذلك، ستسهم هذه المبادرة في مساعدة الخبراء على تحديد ما إذا كان أي من العمال في حالة صحية حرجة تستدعي تدخلاً طبياً عاجلاً أو اتخاذ إجراءات طبية احترازية أو وقائية. ولضمان تحقيق أقصى استفادة من هذه المبادرة وتقديم رعاية طبية شاملة للعمال، سيراعى استخدام أدوات وأجهزة خاصة لمراقبة وتقييم صحة العامل عن بُعد من خلال قياس وزنه، ومراقبة عادات تدخينه، وقوة عضلاته البدنية، وحساب عدد ساعات نومه، بالإضافة إلى تقييم صحته النفسية. وسيستند مشروع مراقبة الصحة على الاستفادة من مخرجات أنشطة تقييم صحة العمال التي أجريت في مواقع العمل، كما سيقدم للعمال نصائح عن أسس التغذية السليمة، بالإضافة إلى عرض مواد تثقيفية مصورة. ولعل أهم ما يميز هذا المشروع هو إتاحة الفرصة أمام العمال للتحدث بلغاتهم مع خبراء تغذية وصحة، والحصول على نصائح صحية وطبية قيمة. ولضمان تحقيق هذا المشروع لأهدافه، ستقدم اللجنة العليا ووايل كورنيل للطب - قطر تدريباً يستهدف مقاولي مشاريع بطولة كأس العالم لكرة القدم قطر 2022، وفرق عمل خدمات تموين الغذاء، ومسؤولي رعاية العمال باللجنة العليا، لتعريفهم بالمشاكل الصحية والغذائية الأساسية التي قد تواجه العمال، والدلائل الإرشادية للتغذية التي أصدرتها قطر عام 2015. قال السيد محمود قطب، المدير التنفيذي لإدارة رعاية العمال في اللجنة العليا للمشاريع والإرث: يسرنا مواصلة التعاون مع نخبة من أفضل الخبراء والمتخصصين في وايل كورنيل للطب - قطر. تضع اللجنة العليا صحة العمال وسلامتهم في قائمة أولوياتها، لذا، سيسهم هذا المشروع الجديد في تعزيز جهودنا في هذا الصدد. ويأتي هذا المشروع ضمن عدة مبادرات أطلقتها اللجنة العليا بهدف المحافظة على صحة عمال مشاريع بطولة قطر 2022. علاوة على ذلك، تعزز مثل هذه المبادرات قرار اللجنة العليا بفرض إجراء فحوصات طبية شاملة لكافة العمال، إذ يتولى حالياً الهلال الأحمر القطري أداء هذه المهمة. بدوره، قال الدكتور جاويد شيخ، عميد وايل كورنيل للطب: يسعدنا مواصلة تعاوننا مع اللجنة العليا في تنفيذ هذا المشروع الرائد. وبدورنا، نشيد بجهود اللجنة العليا ومساعيها الرامية لتحسين صحة العمال. إن استخدام أنظمة وبرامج مراقبة طبية ذات تقنية عالية يضع هذا المشروع في مصاف الجهود الدولية لتعزيز صحة وسلامة العمال. وعوضاً عن ذلك، يُسهم اهتمام اللجنة العليا وحرصها على مشاركة نتائج الفحوصات مع العمال بما لا يدع مجالاً للشك في تشجيعهم على المحافظة على صحتهم وتبني نمط حياة صحي خلال فترة مكوثهم في قطر وبعد عودتهم إلى أوطانهم. من جانبه، قال الدكتور شاهراد طاهري، أستاذ الطب والعميد المساعد للبحوث الاستقصائية الإكلينيكية في وايل كورنيل: يهدف تعاوننا مع اللجنة العليا إلى تحديد المشاكل الصحية والتحديات الفسيولوجية التي قد يواجهها العمال في وقت مبكر، الأمر الذي سيسمح لنا بوضع أنظمة لمعالجة هذه المشاكل بشكل سريع وفعال. وأضاف: أنه يسمح باستخدام نظم المراقبة الطبية المتطورة بتوسيع نطاق مراقبة صحة العمال بسرعة وكفاءة عالية. وسيُسهم هذا المشروع في ترك إرث قيم يخدم عمال المشاريع في أنحاء العالم، كما أنه سيلعب دوراً هاماً في تعزيز وتطوير برامج الصحة والرعاية الاجتماعية في دولة قطر التي تشهد نهضة عمرانية غير مسبوقة. ويعد هذا التعاون فرصة فريدة لإحداث تغيير إيجابي في حياة العمال، وتعزيز مبادرات رعاية العمال التي تطلقها اللجنة العليا.
601
| 23 فبراير 2019

نالت وايل كورنيل للطب اعتماداً رفيعاً هو الأعلى من فئته في مضمار التعليم الطبي المستمر للأطباء من مجلس اعتماد التعليم الطبي المستمر (ACCME)، الذي يُعدّ هيئة الاعتماد الطبية الريادية في الولايات المتحدة الأمريكية. وكان برنامج التعليم الطبي المستمر في وايل كورنيل قد نال أول اعتماد له من مجلس اعتماد التعليم الطبي المستمر بالولايات المتحدة في عام 2016، لتكون الكلية في طليعة كليات الطب التي تنال مثل هذا الاعتماد من خارج الولايات المتحدة. ويمنح هذا الاعتماد الرفيع كلية الطب الحاصلة عليه، حقوق ومسؤولية تخصيص ساعات معتمدة من الفئة الأولى حسب نظام الجمعية الطبية الأمريكية (AMA PRA). وبعد تقييم مستفيض ووافٍ لبرنامج التعليم الطبي المستمر، نالت وايل كورنيل درجة الاعتماد مع الثناء من مجلس اعتماد التعليم الطبي المستمر بالولايات المتحدة. بل إن المجلس المرموق قد قرّر منح الكلية الاعتماد لمدة ستة أعوام، بدلاً من أربعة أعوام كما هو معتاد، تقديراً منه للمعايير الرفيعة لأنشطة التعليم الطبي المستمر التي تطرحها الكلية. وبنيل هذا الاعتماد مع الثناء يمتد الاعتماد الممنوح من المجلس للكلية حتى شهر نوفمبر 2024. وقال الدكتور غرايم ماكماهون، الرئيس والرئيس التنفيذي لمجلس اعتماد التعليم الطبي المستمر بالولايات المتحدة: نوجّه التهنئة إلى وايل كورنيل للطب لحصولها على الاعتماد مع الثناء كأعلى درجة اعتماد يمنحها مجلسنا. ويؤكد هذا الإنجاز تميُّز وايل كورنيل للطب - قطر في مبادراتها الريادية والابتكارية والإبداعية في مجال التعليم الطبي المستمر. ويبرز أهمية التعليم في الارتقاء بأداء الأطباء على نحو ملموس. وعبر تسخير الدور المؤثر للتعليم، فإن الكلية ترسّخ مفاهيم الرعاية القائمة على فريق عمل متكامل والصحة السكانية وتعاون المجتمع ومهارات الاتصال عند الأطباء الممارسين. ولابدّ من الثناء على التزام الكلية بالتطوير المستمر لبرامجها، وتحقيق كل تقدم ممكن في مجال التعليم الطبي المستمر من خلال البحوث العلمية والزمالات. ونحن نتطلع إلى استمرار العمل معاً للارتقاء بأداء الأطباء الممارسين في قطر، ودعم جهود تحسين الرعاية الصحية المتاحة للمرضى وعموم أفراد المجتمع.
1133
| 30 يناير 2019
نشر فريق من الباحثين من وايل كورنيل بقيادة الدكتور ديتريتش بيسلبرج، أستاذ الفسيولوجيا والفيزياء الحيوية، دراسةً متعمّقةً حول فعالية علاجات مشتقة من النباتات في محاربة أكثر أنواع سرطان الثدي شراسةً على الإطلاق. واستعرض الباحثون 353 دراسة علمية لتحديد أي العلاجات المستمدة من نباتات تتسم بخصائص مضادّة للسرطان يمكن أن يُستعان بها في حالة المصابات بسرطان الثدي ثلاثي السلبية. ويعرف هذا النوع من السرطان بشدّة شراسته، وعدم استجابته للعلاجات الهرمونية التقليدية، وقدرته على الانتشار والمعاودة وتطوير مقاومة للعقاقير الدوائية بمعدلات عالية. وقام فريق الباحثين الذي ضمّ كلا من إليزابيث فارجيز، الدكتور سامسون ماثيوز صاموئيل، مريم أبو طالب، الدكتور رافيندر مامتاني، الدكتورة سهيلة شيما بدراسة استقصائية متأنية للبحوث الراهنة تناولت 14 مركّباً نباتياً مختلفاً لها سمات مضادة للسرطان وموجودة في مجموعة واسعة من النباتات، مثل لوتيولين (الموجود في العديد من الأعشاب والخضراوات)، كوركومين (الموجود في الكُركم)، كابسيسين (الموجود في مستخلَص الفلفل الحار)، روتين (الموجود بكثرة في التفاح والتين والحمضيات)، إلى جانب عدد آخر من المركبات الطبيعية. ويُطلق على سرطان الثدي ثلاثي السلبية هذا الاسم بسبب نتيجته المخبرية السلبية الثلاثية بشأن وجود مستقبِلات هرمون الإستروجين، ومستقبِلات هرمون البروجسترون، ومستقبِل عامل نمو البشرة 2 (HER2)، وعليه فإن سرطان الثدي ثلاثي السلبية لا يستجيب للعلاجات الهرمونية وتلك المستهدفة لمستقبِل عامل نمو البشرة 2، وتستهدف مثل هذه العلاجات تلك المستقبِلات وهي فعالة في علاج الأورام غير المنتمية إلى فئة أورام سرطان الثدي الثلاثي السلبية. لذلك يلجأ الأطباء في المقام الأول إلى الجراحة، جنباً إلى جنب مع العلاجين الكيميائي والإشعاعي، وهذه التوليفة العلاجية غير فعالة في العادة إلى جانب آثارها الجانبية المضنية. ومن المعروف أن سرطان الثدي هو السرطان الأكثر شيوعاً بين النساء في العالم، وتُصنف نسبة 10-24% من سرطان الثدي ضمن فئة سرطان الثدي ثلاثي السلبية. ونوّه الدكتور بيسلبرج بالكمّ الوفير من البحوث التي أُجريت حول فعالية نطاق عريض من العلاجات المستخلصة من نباتات في علاج سرطان الثدي ثلاثي السلبية، إلاّ أن قلة قليلة من الأوراق البحثية المنشورة استقصت هذه الدراسات وخرجت برؤية شاملة عنها. وقال: من المثبت أن تناول العديد من الفواكه والخضراوات المتنوعة يقلّل خطر الإصابة بالسرطان، غير أن البحوث عن العلاجات المستندة إلى نباتات ومركبات طبيعية المنشأ مبعثرة ما يجعل استيعابها مسألة مرهقة ومستنزفة للوقت. وتابع قائلاً: سعينا من خلال هذه الورقة البحثية إلى حصر نطاق عريض من أفضل الدراسات في هذا المضمار، وتحليلها واستخلاص استنتاجات بشأن فعالية العلاجات المستخلصة من نباتات. ومن المؤمل أن يسهل ذلك استهداف البحوث، وفي نهاية المطاف الاستعانة بالعلاجات القائمة على نباتات تشير الدلائل إلى أنها تحسّن المحصلة العلاجية للمصابات بسرطان الثدي ثلاثي السلبية. يكمن تأثير المركبات الطبيعية ذات السمات المضادة للسرطان في أنها تعدّل مسارات تأشير الخلايا المختلفة المنخرطة في نمو الخلايا السرطانية. وقام فريق الباحثين بتحليل مسارات التأثير التي تتأثر بكل مركّب من المركّبات قيد الدراسة، ووجدوا أن 13 من أصل 14 مركباً خضعت للدراسة الاستقصائية تتسم بخصائص مضادة لسرطان الثدي ثلاثي السلبية، وهذه المركبات موجودة في قائمة طويلة من النباتات تشمل البروكلي، الفلفل الأخضر الحار، البصل، أوراق البصل، الفجل، الجزر، الكرفس، الطماطم، الكراث، التفاح، الكيوى، الحمضيات، الفاصولياء، الخيار، الكركم، فول الصويا، العنب الأحمر، التوت البري، توت العليق، الفلفل، بعض البقوليات، فُطْر توليبوكلاديوم، ونبتة زنبق الذرة من فصيلة الخربق وهي نبتة ذات سُمّية معتدلة. ووجد الباحثون أن لمركّب أسباراجين من بين 14 مركّباً خضعت للدراسة الاستعراضية الموسّعة، تأثير التهيئة للتسرطُن أو تشكُّل الأورام السرطانية في حالات سرطان الثدي ثلاثي السلبية، ويوجد هذا المركّب في الهليون، البطاطس، البقوليات، إلى جانب عدد من المصادر غير النباتية مثل لحوم الأبقار والأسماك والبيض. وقال الدكتور صاموئيل: استطعنا من خلال البحوث العلمية المنشورة تحديد عدد من المركّبات المستخلصة من نباتات التي يمكنها أن تعوق نمو الأورام عبر تغيير ستّة مسارات معروفة لتأثير خلايا مرتبطة بسرطان الثدي ثلاثي السلبية. وهذه المركبات الطبيعية المنشأ ذات تأثيرات متواضعة نسبياً وحتماً يجب ألا يُنظر إليها كعلاجات بحدّ ذاتها بأيّ حال من الأحوال، غير أنها تتسم بخصائص مضادة للسرطان وعليه يمكن أن تكون عوامل محتملة مضادة للسرطان تستوجب المزيد من البحث والتمحيص.
1223
| 22 يناير 2019

أعلنت وايل كورنيل للطب - قطر عن تمديد مهلة قبول طلبات الانتساب إلى برنامج التدريب حول الطب الحيوي الخاص بالقطريين حتى 20 ديسمبر المقبل.وكانت الكلية قد أطلقت هذا البرنامج في عام 2011 وتخرّج منه حتى الآن 36 باحثة وباحثاً قطرياً. تكمن أهمية البرنامج الذي سيبدأ في يناير 2019 ومدته 6 أشهر، في أنه يتيح للقطريين الجامعيين المتخرجين حديثاً فرصة التعرّف على المختبرات البحثية ذات المعايير العالمية في وايل كورنيل للطب - قطر والعمل مع باحثين معروفين. ويستقطب هذا البرنامج أيضاً حملة الشهادات من مختلف التخصصات.تشمل الحوافز التي يقدمها البرنامج التدريبي حول الطب الحيوي المموّل بالكامل من وايل كورنيل للطب – قطر وينظّم بالتعاون مع برنامج قطر للريادة في البحوث في مؤسسة قطر، شهادة وراتباً ومخصصات أخرى لجميع الملتحقين به، ممّن اختاروا أن يكونوا من عداد العلماء والباحثين الإكلينيكيين والباحثين في الطب الحيوي.
898
| 19 نوفمبر 2018

شارك الدكتور جيريمي أراش رافي تبريزي، أستاذ الطب الوراثي لأمراض النساء والتوليد في وايل كورنيل للطب - قطر، في جراحة طبية جديدة واعدة لسرطان المبيض أُجريت في فرنسا بعد أشهر على اعتمادها. ويعتقد الأطباء أن هذه الجراحة قد تزيد أعداد الناجيات من سرطان المبيض، لذلك يأمل تبريزي في أن يتمكن من نقل هذه الجراحة الابتكارية إلى قطر وأن ينسّق مع مؤسسات طبية قطرية لإطلاق برنامج مبتكر لمعالجة سرطان المبيض في مراحله المتقدمة ولإدخال نهج الطب الشخصي الجديد إلى قطر. وقال الدكتور تبريزي إن سرطان المبيض هو السرطان الأكثر فتكاً بين السرطانات النسائية، فمن المرجح ألا تعيش المصابة بمرحلة متقدّمة منه أكثر من ثلاثة أو أربعة أعوام، وإذا أردنا المقارنة، فمعدّل نجاة مريضات سرطان الثدي يتراوح بين 80 و90%. ويردّ الأطباء نسبة الشفاء الضئيلة من سرطان المبيض إلى أن الأورام تنتشر في البطن، ومثل هذه الفجوة الكبيرة تجعل أعراض سرطان المبيض تمرّ في معظم الأحيان دون أن يتنبّه إليها أحد إلا في مرحلة متقدمة، حينئذ تكون الأورام قد استحكمت وانتشرت بالفعل في أنحاء الجسم. تتمثّل المنهجية العلاجية المتبعة في الوقت الراهن في إزالة الأورام كافةً ومن ثم البدء بالعلاج الكيميائي الوريدي، غير أن معاودة ظهور سرطان المبيض أمر شائع، ويعتقد الدكتور تبريزي أن مردّ ذلك إلى تمكُّن الخلايا السرطانية المجهرية المتبقية من الاختباء في الصّفاق، وهو الغشاء الرقيق المبطّن لجدار البطن من الداخل والمطوّق للأعضاء الداخلية فيه. وفي هذا السياق، قال تبريزي: معظم مريضات سرطان المبيض يعاودهن المرض في غضون ثلاث سنوات بعد العملية، وعندئذ يستلزم الأمر علاجاً كيميائياً إضافياً وفي بعض الأحيان إجراء جراحة ثانية. ولأن نُكْس سرطان المبيض أمر منتشر فإن ذلك يعزز مصداقية نظرية أن الصّفاق يوفر الملاذ للخلايا السرطانية المحتمية فيه من أدوية العلاج الكيميائي. وأضاف قائلاً: طوال الأعوام العشرة الماضية قمنا في مختبري، بدعم من مؤسسة قطر ممثّلةً في برنامج بحوث الطب الحيوي والصندوق القطري لرعاية البحث العلمي، باستقصاء الصلة بين الصّفاق والخلايا السرطانية. وتبيّن لنا أن الخلايا الصّفاقية تنشط خلال الجراحة وتقتنص الخلايا السرطانية ردّ فعل الخلايا الصّفاقية للتملّص من أدوية العلاج الكيميائي. لذا، يتعيّن علينا أن نعطّل هذه الصلة بينهما لتحسين فرص القضاء على سرطان المبيض. وأوضح تبريزي أنه في عام 2004 انضم إلى الأطباء المنخرطين في مفهوم العلاج الكيميائي مفرط الحرارة داخل الصّفاق (HIPEC) في ما يتعلق بسرطان المبيض المتقدّم. ويقوم هذا المفهوم على تسخين أدوية العلاج الكيميائي ومن ثم توجيهها مباشرة إلى فجوة البطن بدلاً من أن يكون ذلك عبر الوريد. وتُحدث الحرارة صدمةً للخلايا السرطانية تقود إلى موتها، كما أن إعطاء العلاج الكيميائي مباشرة في البطن يضمن نسبة تركيز أكبر مقارنةً بإعطائه عبر الوريد. ولكن، من المؤسف أن هذه التقنية لم تكن فعّالة كما أريد لها.
721
| 17 نوفمبر 2018

قال الدكتور رافيندر مامتاني، العميد المشارك الأول للصحة السكانية وبناء القدرات وشؤون الطلاب، وأستاذ سياسة الرعاية الصحية والبحوث في وايل كورنيل ، والمشرف على الباحثين في الدراسة: «يعتبر المجتمع القطري من المجتمعات الناجحة جداً في مجال التعدد الثقافي، فقد استطاع جذب هجرة وافدة بأعلى المستويات من مختلف أنحاء العالم. وفي كثير من الأحيان، تتباين اتجاهات الوفيات بين المجموعات السكانية المختلفة تبايناً كبيراً، لذلك قد نستفيد من التحليل الإضافي لهذه الاتجاهات للحصول على صورة أوضح وأدق للمخاطر الصحية التي يتعرض لها الأفراد. لقد هدفت دراستنا هذه إلى تقييم الاتجاهات الزمنية لمعدلات الوفيات حسب الأسباب الرئيسية لوفيات القطريين وغيرهم من المقيمين، ومن خلال هذا التقييم فإننا سنتمكن من إلقاء الضوء على الاستراتيجيات المحتملة التي تساهم في تجنب الوفيات التي يمكن الوقاية منها لكافة أفراد المجتمع». حلّل فريق الدراسة البيانات المتوفرة المتعلقة بالوفيات، وصنفها بالتفصيل حسب الجنسية والفئة العمرية والجنس وسنة الوفاة، وأضاف الفريق أيضاً تصنيف سبب الوفاة وفقاً لأحدث تنقيح لتصنيف الأمراض التي تستند إليه منظمة الصحة العالمية. وتضمنت الدراسة تحليلاً مفصلاً لمعدلات الوفيات حسب الأسباب الرئيسية في فئتي المواطنين والمقيمين في قطر، واشتملت على بيانات الوفيات على مدى 27 عاماً، خلال الفترة من 1989 إلى 2015، في الفترة التي شهدت فيها قطر نمواً سريعاً في عدد السكان خاصة بعد وصول عدد كبير من العمالة الوافدة. وتشير التقديرات إلى أن معدل النمو السكاني بين عامي 2005 و2010 بلغ حوالي 22%، في حين كان أقل من 4% قبل عام 2000، ونتيجة لهذا النمو فإن 90% من السكان الذين تبلغ أعمارهم أكثر من 15 سنة هم من المقيمين. وأظهرت نتائج الدراسة انخفاض معدلات الوفيات للبالغين القطريين وغير القطريين من الرجال والنساء خلال هذه الفترة. وتُعلل الدراسة ذلك، بتوفر فرص الحصول على خدمات رعاية صحية شاملة وحديثة، وتحسن نوعية التعليم والتنمية الاجتماعية والاقتصادية. وكانت الإصابات الناجمة عن وسائل النقل، وبشكل رئيسي حوادث المرور على الطرق، هي المُسبب الرئيسي لوفيات الذكور من القطريين، وقد لوحظ انخفاض معدل الوفيات في الفئة ذاتها على مدى تلك الفترة وذلك بعد اعتماد الحكومة سلسلة من الإجراءات لتطوير وتحسين جوانب السلامة والأمان للطرق. وكان معدل الوفيات الناجمة عن وسائل النقل خلال هذه الفترة أعلى للذكور القطريين مقارنة بالذكور غير القطريين. وبالنسبة للإناث القطريات وغير القطريات، فقد وجدت الدراسة أن السبب الرئيسي للوفاة كان الأورام وبشكل رئيسي الأورام السرطانية. كما كشفت النتائج عن انخفاض ملحوظ في أعداد الوفيات الناجمة عن السقوط بين الرجال غير القطريين، خلال الفترة من 2001 إلى 2014، فقد انخفضت الأعداد من حوالي 5.1 إلى 2.6 لكل 100,000 حالة وفاة. وأشارت الدراسة إلى أن هذا الانخفاض يعود إلى التحسّن الذي طرأ على بيئة العمل وتوفير السلامة العامة فيها. كما استنتجت الدراسة أيضا أن بيئة العمل للرجال من غير القطريين قد شهدت تطوراً واضحاً مع مرور الوقت، فخلال الفترة من 2010 إلى 2013، قدرت نسبة الوفيات السنوية الناجمة عن الحوادث المميتة وإصابات مواقع العمل، ممن تلقوا علاجهم في المستشفى المتخصص بعلاج الإصابات الخطرة في قطر، بحوالي 1.6 لكل 100,000 حالة وفاة، وهذه النسبة تُعادل نصف ما تم الإعلان عنه في الولايات المتحدة، حيث قدرت النسبة فيها بحوالي 3.4 لكل 100,000 حالة وفاة.كشفت دراسة رائدة أجراها باحثون من قسم الصحة السكانية في وايل كورنيل للطب – قطر، أن الهجرة الوافدة وخصوصاً فئة الشباب الأصحاء بدنياً تساهم بشكل ملحوظ في تخفيض معدلات الوفيات لكافة السكان في قطر. وقد نُشرت الدراسة في الدورية العلمية الدولية المرموقة PLOS ONE، بعنوان «دراسة مقارنة لاتجاهات زمنية لمعدلات الوفيات للمواطنين والمقيمين البالغين في قطر خلال الفترة من 1989 إلى 2015». هدفت هذه الدراسة الحديثة إلى إعطاء صورة أكثر دقة لمعدلات وفيات البالغين في قطر وذلك من خلال استقصاء اتجاهات الوفيات من البالغين القطريين ومقارنتها باتجاهات الوفيات من البالغين المقيمين في قطر ، حيث إن استعراض البيانات الإجمالية لحالات الوفيات، خاصة مع التنوع السكاني الواسع الذي يشهده المجتمع في قطر، لا يتيح سوى معلومات محدودة عن الأسباب الرئيسية التي تسببت بهذه الحالات في كل فئة من فئات المجتمع.
762
| 14 نوفمبر 2018

نظم قسم الصحة السكانية في وايل كورنيل للطب قطر، برنامجاً تدريبياً جديداً حول إتقان الذكاء العاطفي للمختصين في مجال الرعاية الصحية. ويهدف هذا البرنامج إلى تدريب المشاركين على التحكم في عواطفهم وسلوكياتهم وتعزيز معرفتهم بالذكاء العاطفي وبالوعي الاجتماعي، مما يحقق الفائدة في مجال الرعاية الصحية. تضمن البرنامج الذي عُقد على مدى يومين في مقر الكلية سلسلة من العروض تناولت المفاهيم الأساسية للذكاء العاطفي وطرق تقييمه بصورة عامة وتطوير مهارات الوعي الذاتي ومهارات الإدارة الذاتية والوعي الاجتماعي، بالإضافة إلى مهارات إدارة العلاقات مع الآخرين. وتمكن المشاركون في الجلسة الختامية من كتابة خطط عملهم وأهدافهم المتعلقة بتطوير الذكاء العاطفي، كما عبروا خلال جلسة نقاش تفاعلية عن الخبرات والمعرفة التي اكتسبوها من هذا البرنامج. قدم البرنامج كل من السيدة مها النشار، مديرة مركز التوعية الثقافية في الرعاية الصحية التابع لقسم الصحة السكانية في وايل كورنيل للطب قطر، والسيدة هدى عبدالرحيم أخصائية أولى في المركز، المعتمدتين من قبل تالنت سمارت، إحدى أكبر الشركات العالمية في مجال التدريب على الذكاء العاطفي. قالت السيدة مها النشار: يعتبر الذكاء العاطفي من المهارات الضرورية والهامة في مجال الرعاية الصحية، لا سيما في بيئة متنوعة الثقافات مثل قطر. ويمكننا من خلال تطوير الذكاء العاطفي تخطي الفروقات الثقافية في القطاع الطبي، بالإضافة إلى تعزيز الصحة النفسية عند المرضى وزيادة فعالية التواصل وتحسين نتائج الرعاية الصحية ككل. نحن سعداء للغاية بردود الفعل الإيجابية التي تلقيناها من المشاركين، فقد أظهروا الكثير من الانفتاح على مفاهيم الذكاء العاطفي، وعملوا بجد من أجل التعرف على هذه المهارات وكيفية الاستفادة منها في أعمالهم. تشير الدراسات إلى أن الذكاء العاطفي مهم للغاية في القطاع الطبي؛ لأنه يساهم في تعزيز المهارات الاجتماعية ومهارات التواصل بين الأفراد، ويؤدي إلى علاقة أفضل بين المريض والطبيب ويحسّن الأداء ويرفع نسبة زيادة الرضا الوظيفي، كما يضمن حصول الأفراد على خدمات رعاية صحية عالية الجودة. ويمكن أن يساهم التواصل الجيد والاحترام المتبادل بين الأطباء ومرضاهم، في تشجيع المرضى على الحديث عن مشاكلهم الصحية بصورة كاملة واتباع تعليمات الطبيب بدقة. ويعني الذكاء العاطفي أن الأفراد يستطيعون إدراك عواطفهم والتحكم فيها وفهمها وإدارتها بطرق إيجابية، مما يتيح لهم التعامل مع المواقف العصيبة بشكل أفضل وتحسين مهارات التواصل والتعاطف لديهم.
540
| 31 أكتوبر 2018
مساحة إعلانية
الأكثر مشاهدة

يشهد قطاع النقل العام في دولة قطر تطوراً ملحوظاً من حيث تنوع الوسائل واعتماد أحدث التقنيات، في إطار تنفيذ خطط ومبادرات استراتيجية تهدف...
13352
| 26 أبريل 2026

بدأت شركات الطيران العربية والأجنبية عملياتها تدريجياً من مطار حمد الدولي اعتباراً من الثلاثاء الماضي 21 أبريل 2026 عقب الإعلان الصادر عن الهيئة...
6434
| 27 أبريل 2026

أعلنت الهيئة العامة للضرائب عن توفير تسهيلات خاصة بالإقامة الضريبية للمقيمين والمستثمرين في ظل الأوضاع الاستثنائية، موضحة أن شهادة الإقامة الضريبية تعد وثيقة...
5170
| 28 أبريل 2026

حمل تطبيق الشرق
تابع الأخبار المحلية والعالمية من خلال تطبيقات الجوال المتاحة على متجر جوجل ومتجر آبل
الأكثر رواجاً
- 1 بينها مصر للطيران .. شركات طيران جديدة تستأنف رحلاتها عبر مطار حمد الدولي
أعلن مطار حمد الدولي استمرار التوسع في عمليات الطيران، مع استئناف المزيد من شركات الطيران الدولية تسيير رحلاتها من وإلى الدوحة. ودعا المطار...
4636
| 26 أبريل 2026
- 2 إغلاق مطبخ شهير بالوكرة وبقالة بروضة راشد بعد ضبط أغذية في ظروف غير صحية
أعلنت وزارة البلدية عن إغلاق مطبخ شهير بالوكالة وبقالة في روضة راشد، لمخالفة قانون تنظيم الأغذية الآدمية رقم 8 لسنة 1990 بشأن تنظيم...
4512
| 26 أبريل 2026
- 3 قطر للطاقة تعلن عن فتح باب التقديم للبعثات الجامعية داخل وخارج قطر
أعلنت قطر للطاقة مجدداً عن فتح باب التقديم للبعثات الجامعية داخل وخارج قطر، للقطريين فقط، موضحة أن آخر موعد للتقديم 21 مايو 2026...
3194
| 26 أبريل 2026



